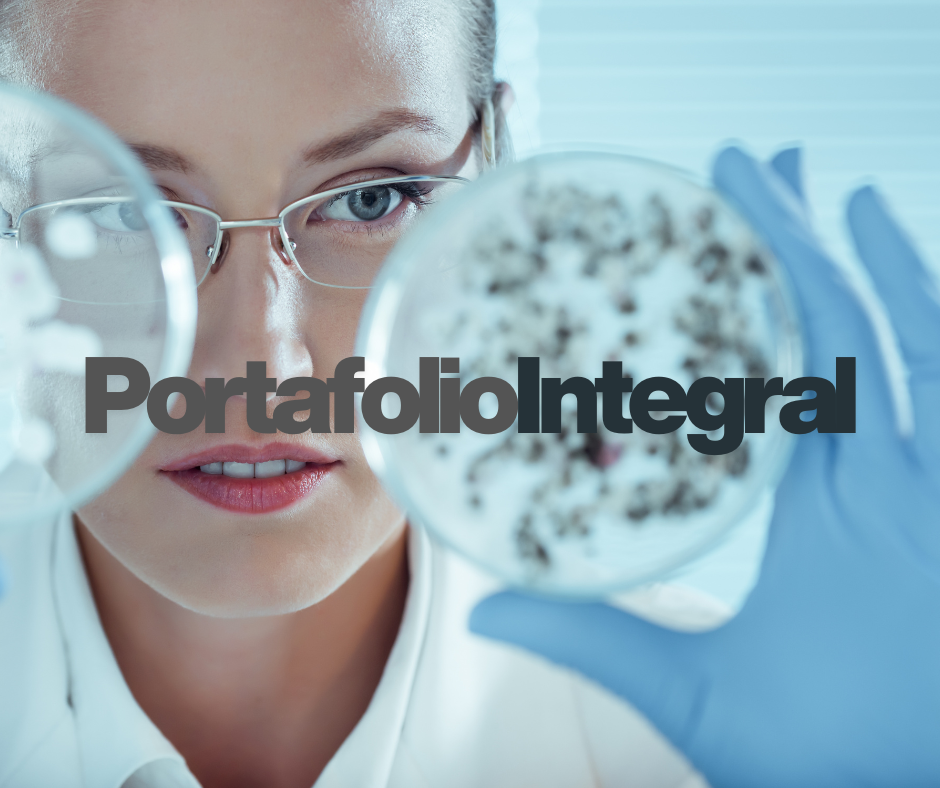
2

Llevamos salud a cada rincón de México, garantizando medicamentos de calidad y un servicio confiable.
Una Empresa Familiar 100% mexicana, buscando y proponiendo soluciones y alternativas para los padecimientos de salud que afectan a la población, Comprometida para que cualquier persona pueda tener acceso a los servicios y medicamentos que mejoren su salud. Dedicada a brindar servicios de compra, venta, comercialización, distribución, importación y exportación de todo tipo de bienes y servicios, entre los que se incluyen principalmente medicamentos, dispositivos médicos, agentes de diagnóstico, materia prima y reactivos.
¿Quiénes Somos?

En MEDIVIDA contamos con una sólida y bien estructurada red de distribución que opera en todo el territorio nacional. Nuestro alcance abarca cada uno de los estados de la República Mexicana, permitiéndonos llegar de manera oportuna a cualquier punto del país.
Gracias a una logística eficiente, confiable y cuidadosamente planificada, aseguramos la entrega puntual de medicamentos, insumos para la salud y material de curación a nuestros clientes, tanto del sector público como privado. Nuestro compromiso es garantizar que cada pedido llegue en tiempo, forma y bajo las condiciones óptimas de seguridad, contribuyendo así al bienestar y cuidado de la salud de la población.
MISIÓN
VISIÓN
